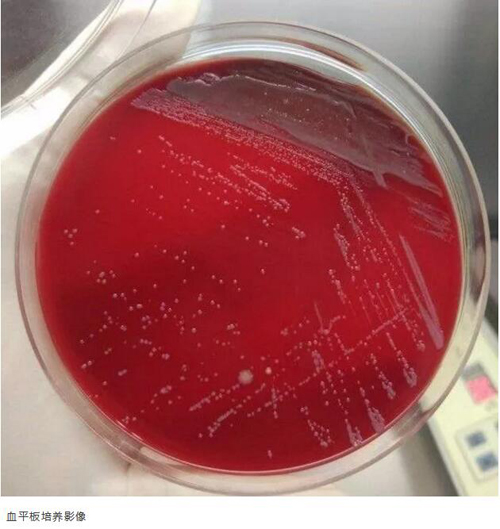

- 活动公告更多>>
-
- 警惕医托!一封患者和家属必读的信 05-20
- 8万人患病 6万不自知 09-29
- 过年催结婚 当心出癔症 02-11
- 用心思考,带思想来工作 10-13
- 人体重要的内分泌器官——甲状腺 09-06
- 简述单纯性疱疹病毒 06-24
- 典型案例更多>>
作者: 时间:2019-10-23 出处:神经内一科 编辑:lsw 点击次数:4365
布鲁氏菌病是由布鲁氏菌属细菌引起的人畜共患传染病,因其传染源多为羊、牛、猪等哺乳动物,所以多流行于畜牧业发达的地区,其他地区少见。而在布氏杆菌病引起的各种症状中,中枢神经系统受累的患者仅占布氏杆菌病患者总数的3.5%~13%,这导致了我国西北、东北、青藏高原及内蒙古之外的其他地区,容易忽视中枢神经系统疾病为布鲁氏菌病引起的可能。
神经型布鲁氏菌病早期临床表现多种多样,部分临床特征与病毒性脑炎相似,而患者脑脊液检查可出现颅内压升高,白细胞计数增多,葡萄糖和氯化物降低等特点,容易经验性的诊断为结核性脑膜炎。在临床表现无明显特异性的情况下,细致地询问患者流行病学史是明确诊断的重要环节。近期从我科出院的患者袁某某,即是在经过正确鉴别诊断和治疗后,最终改善症状并痊愈出院。
患儿袁某,男,13岁1月,两个月前无明显诱因出现发热,最高体温39.8°左右,发热数天后开始出现四肢抽搐,每天发作约5-6次,每次持续约1.5小时。之后症状逐渐加重,开始出现双下肢乏力、疼痛,抽搐发作时伴有意识不清,表现为牙关紧闭,头向右倾斜,双眼上视,伴面色苍白、出冷汗。当地医院头颅MRI平扫增强提示右侧额叶部分脑回异常信号及邻近软脑膜增厚并强化,考虑中枢感染可能,给予丙球、抗感染等常规治疗一月后,肌体抽搐较前减轻,但仍反复发热,伴眼痛,双下肢疼痛。为进一步诊治,患者来广东三九脑科医院神经内一科住院治疗。
入院后,主管医生王玉周副主任医师根据外院诊查资料,分析:患儿因反复发热、抽搐1月入院,外院头颅MRI提示软脑膜增厚并强化,查体:双侧腋窝及颈部多发淋巴结肿大,质软,活动性可,肝脾肋下可触及,四肢肌力肌张力正常,余神经科查体无明显异常。考虑患者在外院按病毒性脑炎治疗后无明显好转,且有反复发热、抽搐、乏力、多汗、肌痛、眼痛、淋巴结肿大等症状表现,诊断上需与动物源性传染病所导致中枢神经系统损害、其他常见的细菌性脑膜炎等进行鉴别。
入院后完善相关检查,ASL检查提示双侧额顶叶、纵裂池内多发条状高灌注;腹部彩超提示脾大,余未见明显异常。

脑脊液检查提示异常脑脊液细胞学,呈混合细胞反应型,以淋巴细胞为主;脑脊液生化:氯(CL-),119.5mmol/L,低。

在对患儿的血液标本进行培养的过程中,我院检验科发现血平板长出湿润、灰色、针尖大小菌落,培养约48小时后则发展为圆形、凸起、光滑、较小的灰色菌落。根据丰富的检验检查经验,判断该病菌极有可能属于布鲁氏菌属细菌。
根据检验线索,继续追问流行病学史,患儿家庭确认近期无接触羊、牛、猪等牲畜,无食用生肉等不洁食物,但是当问及是否接触过生奶制品时,却表示患儿有饮用生羊奶的习惯。由于在此之前家属一直认为饮用生羊奶有益健康,就忽略告知这一重要的流行病学证据。根据患者家属表述,不排除此次发病为羊种布鲁氏菌引起的神经型布鲁氏菌病。
随后进行布鲁氏菌初筛,虎红平板凝集实验:+++。布鲁氏杆菌试管凝集实验:1:400++,结合患者症状表现,明确诊断为神经型布鲁氏菌病。

在予以多西环素合用利福平,加用头孢他啶三联抗布鲁氏菌后,患儿已无发热、无抽搐,症状明显改善,已痊愈出院。
神经内一科王展航主任表示:布鲁氏菌病是一种人畜共患的全身性乙类传染性疾病,发病后可以出现发热、关节痛、神经痛等症状,如果没有得到及时的病因治疗,疾病易由急性发展为慢性,导致迁延难治,严重影响生活质量,甚至丧失劳动能力,所以在有些地方将该病称为“懒汉病”。
经皮肤黏膜直接接触感染是最主要的传染方式,另外布鲁氏菌属细菌也可以经消化道、呼吸道感染。除了职业人群容易在接触病畜时感染之外,其他人也有可能因为食用生奶制品、食用未熟的肉或是受污染的食品导致发病。虽然布鲁氏菌属细菌有较高的抗灭活能力,在自然界中可以存在很长时间,但对湿热、紫外线、消毒剂、抗生素等比较敏感,尤其在湿热100℃的条件下,仅可生存1-4分钟。
预防布鲁氏菌病,职业人群在接触羊、牛、猪等牲畜时应穿着防护装备,普通人群在生活中则应养成良好的生活习惯,避免食用生奶或生肉等。
